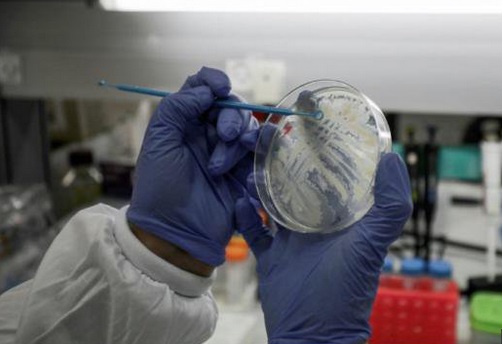

-
Attaques et ripostes: Les opérations militaires s'intensifient entre l'Inde et le Pakistan
-
L'impact de la guerre commerciale sur la Chine moins fort que prévu en avril
-
Trêve à Gaza/Nouveaux pourparlers au Qatar: Aucune percée selon des sources proches du Hamas
-
Zelensky salue un accord "équitable" avec Washington
En mars, le gouvernement allemand a dû se mobiliser de tout son poids pour stopper des approches, en vue d'un rachat, pilotées en pleine pandémie par la Maison Blanche. Et depuis l'heure est à la vigilance accrue.
Au-delà, c'est toute l'Europe, fragilisée par l'épidémie, qui est en train de muscler ses garde-fous face aux projets d'acquisition d'entreprises stratégiques par des groupes étrangers en quête de bonnes affaires.
La Commission européenne vient récemment d'exhorter les 27 pays de l'UE à "se protéger" face à cette menace.
Et mardi, le commissaire européen au marché intérieur a appelé le secteur du tourisme en particulier "à se protéger des stratégies d'investissement agressives des pays non européens qui pourraient voir dans la crise actuelle l'opportunité d'acquérir des joyaux européens à moindre prix".
Si un mécanisme européen adopté en avril 2019 prévoit déjà de mieux surveiller ce type d'investissements, sa transposition dans les droits nationaux a désormais revêtu un caractère d'urgence.
L'Europe "veut empêcher que des entreprises d'importance stratégique, dotées de technologies clés ou importantes pour l'économie nationale, et dont la valorisation est actuellement faible, soient reprises", explique à l'AFP Ulrich Wolff, avocat associé chez Linklaters à Francfort.
L'Allemagne a anticipé le pas et veut à l'avenir vérifier si un projet d'acquisition par un acteur étranger dans un secteur sensible a du poids sur son territoire, mais aussi dans d'autres pays de l'UE, selon un projet de loi adopté début avril.
La première économie d'Europe a aussi introduit la règle du "gun jumping" qui, à l'image d'un coureur sanctionné pour un départ avant le coup de pistolet, interdit aux acheteurs et vendeurs de démarrer tout transfert d'actif "avant que les ministères concernés aient donné leur feu vert", ajoute M. Wolff.
La France a elle abaissé de 33 à 25% le seuil de détention à partir duquel un dossier de reprise doit être soumis à autorisation de l'Etat, l'Allemagne l'ayant elle déjà passé à 10% en 2018. Et deux nouveaux secteurs désignés comme stratégiques, la sécurité alimentaire et la presse, ont été rajoutés à ceux déjà existants.
Paris veut aussi protéger ses entreprises si elles sont convoitées par des acteurs basés dans l'Union européenne, et ce à partir d'une prise de détention majoritaire. Ici, Berlin n'est pas allé aussi loin.
L'Espagne a légiféré deux fois au mois de mars pour mieux surveiller les mouvements de capitaux venus de l'étranger et l'Italie a annoncé début avril vouloir étendre le mécanisme du "golden power" en vigueur depuis 2012. Il donne à l'exécutif des pouvoirs de contrôle dans de nouveaux secteurs considérés comme stratégiques à côté de ceux traditionnels de la défense ou des télécoms.
Sont désormais concernés "la finance, l'assurance, l'énergie, le transport, l'eau, la santé, la sécurité alimentaire, l'intelligence artificielle, la robotique", a énoncé le chef du gouvernement italien, Giuseppe Conte.
L'UE devra surtout se méfier de "pays, dont la Chine, qui opèrent différemment sur le plan économique et qui ne sont pas des partenaires dans la politique de sécurité", explique à l'AFP Mikko Huotari, directeur de Merics, un institut berlinois spécialisé sur la Chine.
Si les investissements chinois dans l'UE ont globalement diminué ces trois dernières années, "l'intérêt pour l'accès stratégique aux technologies est resté", ajoute-t-il.
Le conglomérat chinois Citic vient de passer de 30 à 57% sa participation dans Medea, l'un des principaux groupes de presse tchèques.
La Chine n'est pas de loin le seul pays ayant des velléités en Europe. L'action du groupe Nokia a bondi récemment sur des rumeurs prêtant à un fonds saoudien des velléités d'OPA.
Et selon le Financial Times, des fonds souverains du Golfe, dont le Fonds d'investissement public d'Arabie saoudite et le Mubadala d'Abou Dhabi, se mobilisent, eux, en vue d'emplettes à bon marché dans les secteurs de la santé, les technologies et la logistique.